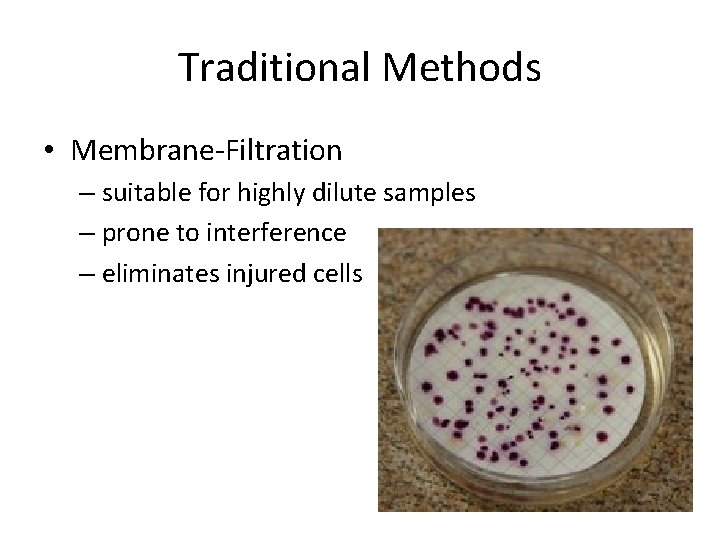
Traditional Methods • Membrane-Filtration – suitable for highly dilute samples – prone to interference

COLIFORMS Indicator Bacteria and Water Quality Testing FECAL

COLIFORMS Indicator Bacteria and Water Quality Testing

FECAL POLLUTION • Exposure to fecally contaminated water does not always translate into infection. However, the higher the fecal bacterial levels in water, the higher the chances of pathogens to be present in significant numbers too. • Among the diseases associated with poor microbial water quality, those causing dehydrating diarrhea are of critical importance as they could lead to death within 48 hours after the initial symptoms. These extreme cases are more predominant in countries where overcrowding and poor sanitary conditions are the norm. • Examples of fecal waterborne diseases are gastroenteritis, typhoid and paratyphoid fevers, salmonellosis, cholera, meningitis, hepatitis, encephalitis, amoebic meningoencephalitis, cryptosporidiosis, giardiasis, dysentery, and amoebic dysentery (Table 3 From Jorge W. Santo Domingo, Nicholas J. Ashbolt (Lead Author); Avanish K. Panikkar (Topic Editor). "Fecal pollution of water". In: Encyclopedia of Earth. Eds. Cutler J. Cleveland (Washington, D. C. : Environmental Information Coalition, National Council for Science and the Environment). [First published in the Encyclopedia of Earth March 18, 2010; Last revised Date March 18, 2010; Retrieved October 10, 2010 <http: //www. eoearth. org/article/Fecal_pollution_of_water>

Table 3. Examples of waterborne pathogens Major diseases Major reservoirs and primary sources Salmonella typhi Typhoid fever Human feces Salmonella paratyphi Paratyphoid fever Human feces Other Salmonella Salmonellosis Human and animal feces Shigella spp. Bacillary dysentery Human feces Vibrio cholera Cholera Human feces and freshwater zooplankton Enteropathogenic E. coli Gastroenteritis Human feces Yersinia enterocolitica Gastroenteritis Human and animal feces Campylobacter jejuni Gastroenteritis Human and animal feces Leptospira spp. Leptospirosis Animal and human urine Various mycobacteria Pulmonary illness Soil and water Name of micro-organisms Bacteria

Table 3. Examples of waterborne pathogens Major diseases Major reservoirs and primary sources Polio viruses Poliomyelities Human feces Coxsackie viruses A Aseptic meningitis Human feces Coxsackie viruses B Aseptic meningitis Human feces Echo viruses Aseptic meningitis Human feces Norovirus Gastroenteritis Human feces to fomites and water Rotaviruses Gastroenteritis Human feces Adenoviruses Upper respiratory and gastrointestinal illness Human feces Hepatitis A virus Infectious hepatitis Human feces Hepatitis E virus Infectious hepatitis; miscarriage and Human feces death Name of micro-organisms Enteric viruses

Table 3. Examples of waterborne pathogens Major diseases Major reservoirs and primary sources Acanthamocba castellani Amoebic meningoencephalitis Human feces Balantidium coli Balantidosis (dysentery) Human and animal feces Cryptosporidium homonis, C. parvum Cryptosporidiosis (gastroenteritis) Water, human and other mammal feces Entamoeba histolytica Amoebic dysentery Human and animal feces Giardia lamblia Giardiasis (gastroenteritis) Water and animal feces Naegleria fowleri Primary amoebic meningoencephalitis Warm water ascariosis Animal and human feces Name of micro-organisms Protozoa Helminths Ascaris lumbricoides Adapted from Ashbolt, 2004

Indicator Organisms • organisms that behave in approximately the same manner as the pathogens of concern, but are present in higher numbers or are otherwise easier to detect

Indicator Organisms • A good indicator microorganism has qualities which make it … – Easy to test for in the lab. – Present in greater numbers than the pathogens they indicate. – Safer to work with in the lab than pathogens since the indicators cause no or only mild illnesses. • Indicators must not only be easy to work with in the lab, they must also predict the presence of pathogens. • Coliform bacteria are good indicators because they only reproduce in the intestines of animals, so they will not be present in water unless the water has been contaminated with sewage. • Coliform bacteria are also able to survive outside animals' intestines, so they will be present in water for several days after the water has been contaminated.

Indicator Organisms • Total Coliforms • Fecal Coliforms • E. coli • Fecal Streptococci • Enterococci

Indicator Organisms • Total Coliforms – not all from fecal origin • Fecal Coliforms • E. coli • Fecal Streptococci • Enterococci

Indicator Organisms • Total Coliforms – not all from fecal origin • Fecal Coliforms – grow at higher temps • E. coli • Fecal Streptococci • Enterococci

Indicator Organisms • Total Coliforms – not all from fecal origin • Fecal Coliforms – grow at higher temps • E. coli – best indicator of health risk • Fecal Streptococci • Enterococci

Indicator Organisms • Total Coliforms • Fecal Coliforms • E. coli • Fecal Streptococci – previously used to test for human origin • Enterococci

Indicator Organisms • Total Coliforms • Fecal Coliforms • E. coli • Fecal Streptococci – previously used to test for human origin • Enterococci – best indicator for salt water

Escherichia coli • E. coli normally colonizes an infant's gastrointestinal tract within 40 hours of birth, arriving with food or water or with the individuals handling the child. • In the bowel, it adheres to the mucus of the large intestine. It is the primary facultative anaerobe of the human gastrointestinal tract. • As long as these bacteria do not acquire genetic elements encoding for virulence factors, they remain benign commensals.

Definitions of (Total) Coliforms • Multiple-Tube Fermentation – All aerobic and facultative anaerobic, Gram-negative, non-spore-forming, rod shaped bacteria that ferment lactose with gas and acid formation within 48 hr. at 35 C. • Membrane Filtration – All aerobic and many facultative anaerobic, Gramnegative, non-spore-forming, rod-shaped bacteria that develop a red colony with a metallic sheen within 24 hr. at 35 C on an Endo-type medium containing lactose.

Other Properties • β-galactosidase positive – Enzyme that hydrolyzes lactose into glucose and galactose • Oxidase negative – Indicates the absence of Cytochrome-c in the electron transport chain.

Typical Coliform Genera • • • Citrobacter Enterobacter Escherichia Hafnia Klebsiella Serratia

Typical Coliform Genera • • • Citrobacter Enterobacter Escherichia Hafnia Klebsiella Serratia Enterobacteriacea

Traditional Methods • Multiple-Tube Fermentation – very low-tech – flexible – depends on growth – slow
Traditional Methods • Membrane-Filtration – suitable for highly dilute samples – prone to interference – eliminates injured cells

Enzymatic Methods • Coliform specific enzymes – -Galactosidase (lac. Z) –total coliforms • Ability to breakdown lactose – -D-Glucuronidase (uid. A) –fecal coliforms • Ability to breakdown complex sugars

Enzymatic Methods • Presence / Absence Tests – like MTF but with enzymes

Enzymatic Methods • Membrane Filtration – more specific than traditional method so it does not require confirmation steps

Enzymatic Methods • Direct Fluorimetry – Similar to presence/absence test but fluorescence is monitored over time to determine relative numbers of bacteria • Solid-Phase Cytometry – Filtered cells are induced and exposed to fluorescent substrate. – Scanning fluorimeter detects individual cells and micro-colonies.

Molecular Methods • Nucleic Acid based techniques – Polymerase Chain Reaction (PCR) • • phylogenetic primers enzyme specific primers detection limit viability

Molecular Methods • Nucleic Acid based techniques – In Situ Hybridization • radioactive vs. fluorescent • very high-tech
- Slides: 26